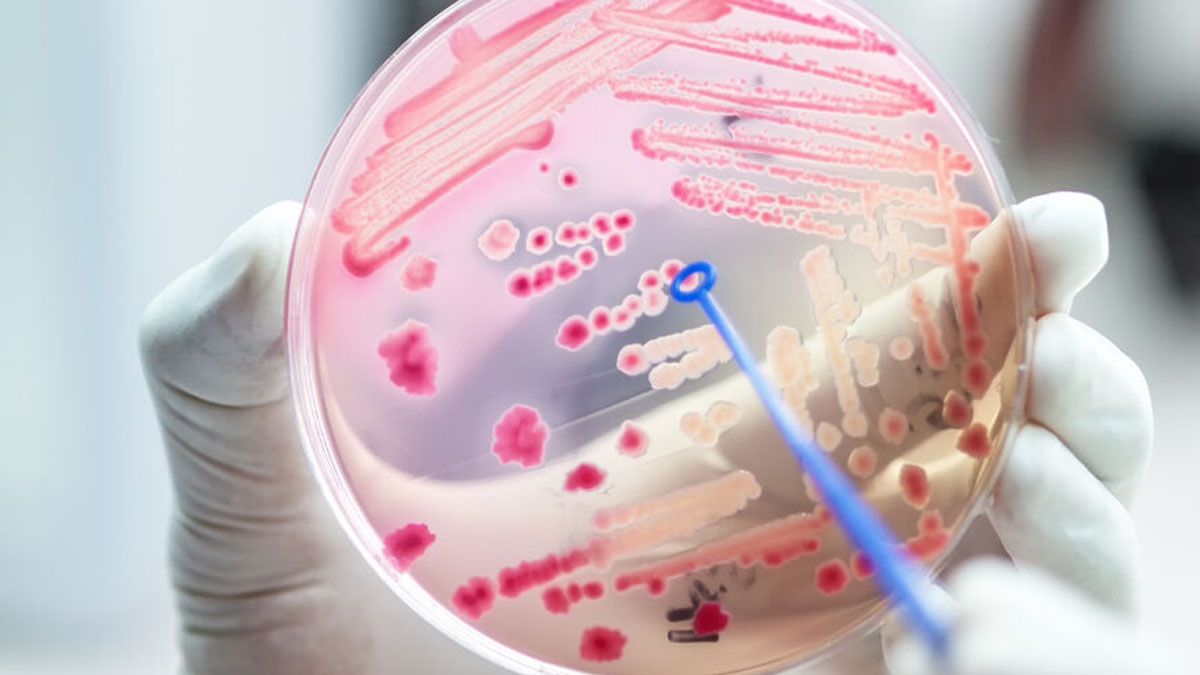
Presentan un fármaco para combatir a las superbacterias

alexander fleming.jpg
Alexander Fleming, descubridor de la penincilina. El padre de los antibióticos. (Foto: A24.com)
Una herramienta exitosa contra las "superbacterias"
El uso de los antibióticos ha hecho un camino inverso a lo que recomendaba Fleming. Se lo ha utilizado más de lo necesario y mal. Especialmente, cuando por otro flagelo, la automedicación, una persona toma un antibiótico (el más común es la amoxicilina) sin saber realmente que problema de salud tiene. Si es algo producido por un virus, los antibióticos son totalmente inútiles.
Pero para las bacterias, es una oportunidad para "aprender y capacitarse" en su lucha por enfermar a un ser vivo. Reconocen ese fármaco y van desarrollando la manera de hacerse inmunes a él. De manera que cuando sea realmente necesario indicar un antibiótico, será esteril: la bacteria será inmune por completo y continuará el proceso de infección.
Ahora, Pfizer junto con Abbvie, dos laboratorios norteamericanos desarrollaron un nuevo antibiótico que por lo menos, parece ser una barrera efectiva contra las "superbacterias". Mientras la bioquímica sigue el desarrollo contra reloj de mejores y más eficientes antibióticos.
Se llama "Emblaveo" y en realidad es un nuevo fármaco gracias a la combinación de dos moléculas ya existentes en el mercado. Es, en realidad, un nuevo medicamento formado por la combinación de dos moléculas ya presentes en el mercado. Se trata de "aztreonam" y "avibactam". Uno de los graves problemas de la salud pública son las enfermedades intrahospitalarias que se dan, justamente, porque hay antibióticos que ya no resultan eficientes ante determinadas bacterias.
Las bacterias actúan sobre enzimas que están clasificadas en cuatro tipos, de la "A" a la "D". Los dos laboratorios hicieron un hallazgo esperanzador. El “avibactam" es un inhibidor de algunas de estas enzimas, pero no da resultado frente a la "B". Allí la bacteria encuentra el "campo fértil" para desarrollar la infección.
Entonces, con la fusión del "aztreonam", el nuevo fármaco protege ante estos 4 tipos de enzimas. En los tratamientos, ya demostró su eficiencia como antibiótico para determinado grupo de pacientes, sin la resistencia de las bacterias.
resistencia antimicrobiana.jpg
El problema de los antibióticos de "amplio espectro"
A medida que las bacterias se han ido volviendo más y más resistentes, la OMS comenzó a alertar con este grave peligro para el ser humano. De seguir por este camino, estima que para 2050, las "superbacterias" serán responsables de la muerte de 10.000.000 de personas por año.
Es por eso que en los hospitales se aplican antibióticos de amplio espectro para tratar a un paciente hasta que se precisa cuál es la bacteria que está infectando. O cuando el paciente no responde como se espera. Pero este procedimiento también ayuda a que las bacterias, al replicarse, vayan desarrollando una mayor capacidad de resistencia.
Por eso la importancia de avances como éste. Aplicar el antibiótico adecuado evita utilizar otros que no son necesarios y solo "alimentan" la información de las bacterias.
origen de superbacterias.jpg
La paradoja de la salud para el desarrollo de los antibióticos
Durante años recientes, muchos laboratorios desistieron de investigar en determinados fármacos. Para qué invertir mucho dinero en un producto que, finalmente, se va aplicar en casos puntuales. La ecuación costo-beneficio no era provechosa. Pero esta política favoreció que aplicar antibióticos de amplio espectro en lugar del específico, aumentó el poder de las "superbacterias".
Por fortuna, ese camino se está desandando. Investigar para producir el fármaco adecuado es mejor, no favorece a las bacterias y permite ganar tiempo en la investigación biomédica.
Si se evitan en lo posible nuevas infecciones -con fármacos o nuevas vacunas-, se gana tiempo y se reduce el uso de antibióticos. Por lo tanto, si se trata cada infección con el remedio adecuado, se ralentiza el desarrollo de la resistencia de las "superbacterias".
En la repetición de ese círculo virtuoso, la biomedicina podrá avanzar para que siga mejorando la calidad de vida del ser humano. En resumen, aplicar en serio, las palabras del padre de los antibióticos, Alexander Fleming.